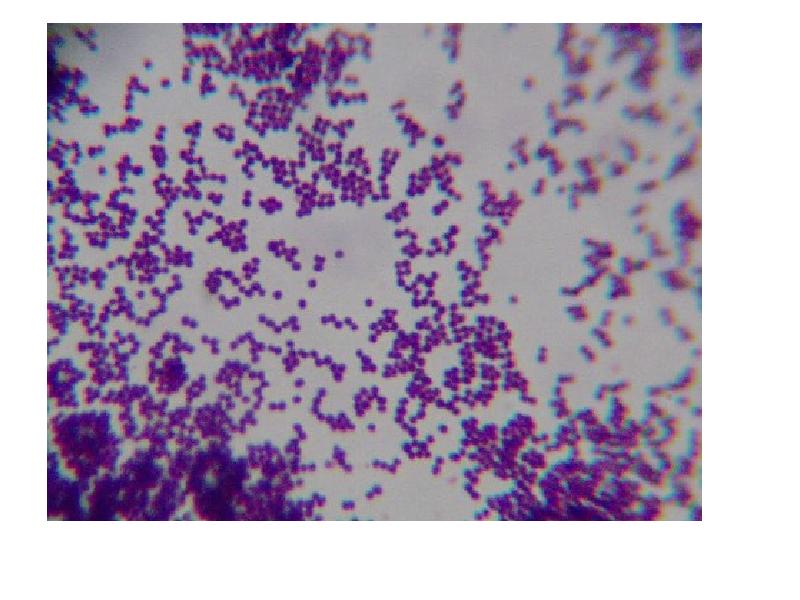
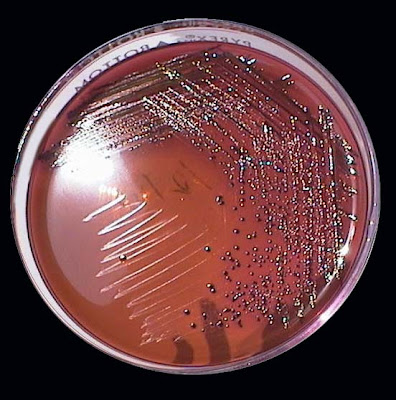

Энтерококк Кандида

🛑 👉🏻👉🏻👉🏻 ВСЯ ИНФОРМАЦИЯ ДОСТУПНА ЗДЕСЬ, ЖМИ 👈🏻👈🏻👈🏻
Купить Элидел в Микунь
Купить Колофорт в Артёме
Купить Костарокс в Нововоронеже
Купить Фервитал метро Бауманская
Энтерококк Кандида





























































































🛑 👉🏻👉🏻👉🏻 ВСЯ ИНФОРМАЦИЯ ДОСТУПНА ЗДЕСЬ, ЖМИ 👈🏻👈🏻👈🏻
Купить Элидел в Микунь
Купить Колофорт в Артёме
Купить Костарокс в Нововоронеже
Купить Фервитал метро Бауманская
Энтерококк Кандида